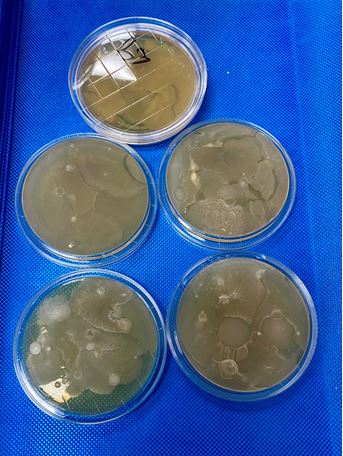
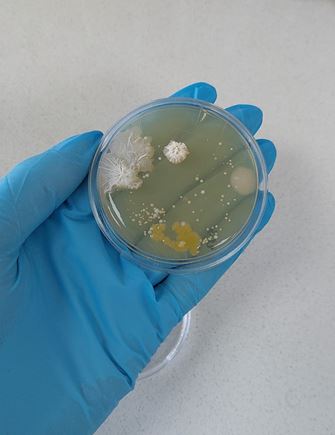

Micro-organisms: Parrots, budgies, cockatiels, finches
Micro-organisms and Your Parrots. How they Interact and How to Control them.
By: Prof Rob Bragg
Dept of Microbiology and Biochemistry
University of the Free State
Bloemfontein
9300
Micro-organisms Introduction
The world around us, and your parrots are filled with microscopic forms of life. These include bacteria, viruses, fungi and protozoa. Fortunately for us, and the birds, most of the micro-organisms around us do not cause any damage or diseases. In fact, the health of the bird can be drastically affected if the natural microbial populations (now referred to as microbiota, but previously known as micro-flora) are destroyed. The natural microbiota plays a very important role in the protection of your birds from invasion by disease causing micro-organisms.
In these articles, I will concentrate on the different disease causing (pathogenic) organisms. I will explain the difference between a primary pathogen and an opportunistic pathogen. I will also give a very brief indication of the diseases caused by the different pathogens and how these diseases can de diagnosed.
The bulk of these articles, will, however, be concentrated on the different approaches to controlling diseases. There are two basic approaches to diseases control. These are treatment and prevention. The old saying ”Prevention is better than cure” is particularly true when dealing with your expensive collection of parrots.
Pathogens and pathogenicity
Fortunately not all micro-organisms are pathogenic. It is estimated that up to 10% of the body weight of any animal (including humans) or bird is made up of bacteria. It has been suggested that our bodies (and that of your birds) contain more bacterial cells than human (or bird) cells. If all of these bacteria were diseases causing, there would be no life on earth anymore.
The disease causing micro-organisms, although relatively few in numbers, can cause very serious disease outbreaks and can cost a huge number of human deaths and significant losses in any animal production system. We just need to think of the serious impact of avian influenza in the poultry industry in South Africa in 2023.
The diseases of any species can basically be divided into two main categories. These are the infectious diseases and the non-infectious diseases. The infectious diseases are those, which are caused by some form of microscopic agent or pathogen. The non-infectious diseases are caused by a variety of things and can include toxins, (from food, plants or cages) heart attacks and other physiological diseases not caused by micro-organisms. These non-infectious diseases will not be discussed further in these articles, apart from a gentle reminder that avocado is highly toxic to parrots. The fumes from non-stick cookware can also kill you bird very quickly! Automatic self cleaning ovens give off toxic fumes and any product containing tea tree oil is toxic for birds. A full list of things which can be toxic to birds include:
Chocolate, mushrooms, alcohol, caffeine, salt, onions and garlic, apple seeds, bried beans, fruit pips, xylitol (often in products like ice cream), peanuts (if contaminated with fungi), Rhubard, tomatoes, aerosols, ammonia, insecticides.
The agents, which can cause the infectious diseases, can be divided into different groups according to the nature of the pathogen which causes the disease. Normally infectious diseases are divided into diseases caused by bacteria, viruses and fungi. The main reason for this division is that each of these groups of micro-organisms have very different ways of growing and replicating and this results in differences in the ways the diseases caused by these pathogens can be treated.
The pathogens can be further subdivided into so called primary pathogens and opportunistic pathogens. Most of the viruses, which can infect your parrots will be regarded as primary pathogens. While most of the bacteria and fungi will be regarded as opportunistic pathogens. The main difference between a primary pathogen and an opportunistic pathogen is the way in which they cause disease. A primary pathogen will normally cause a disease as soon as it comes into contact with the host, irrespective of the physiological state of the host.
In other words, if you parrots become exposed to, for example, Beak and Feather Disease Virus, the birds will most likely become infected with the virus and there will be an outbreak of disease. The primary pathogens do not need anything else to allow them to infect the host. Primary pathogens will not normally be found on or near healthy birds. If the primary pathogen is found on or near your birds, it is a strong indication that your birds are diseased.
Opportunistic pathogens, on the other hand, can normally be found associated with your birds or can be found in the cages and environment around your birds. When the bird is placed under stress, the opportunistic pathogens take the opportunity to attack the weakened bird and cause disease. There are any number of stress situations which can allow the opportunistic pathogens to attack. These can include infection by primary pathogens, handling and moving birds, start of the breeding season and any other changes to the normal routine of the birds.
Micro-organisms: Different groups of pathogens
- Viruses

Electron microscope image of a virus – in this case a coronavirus. There are a number of coronaviruses which can infect birds.
Viruses are the ultimate intracellular parasite. They are very small and cannot even be seen through the most powerful light microscope. Normally they consist only of a protein shell, which protects the genetic material of the virus. Viruses are not capable of living freely in the environment, although some of them can survive for some time outside the host cell. The way that a virus replicates is by insertion of its genetic material into the host cell. The genetic material then forces the cellular machinery of the host cell to make new viruses. The end result is that the cell becomes full of viruses and the cell bursts, releasing thousands of viruses into the host, each of which attack a new cell and the cycle starts again. The actual disease in the host is a result of serious cellular damage to the host caused by the replicating viruses.
The well-known viral diseases of parrots include Psittacine Beak and Feather Disease (PBFD), Paramyxovirus (Newcastle disease), Pachecos Disease, Polymavirus, Wasting disease or proventricular Dilatation disease, and Papilloma virus. As can be seen from the above list, this is the real who’s who in the parrot disease world. These are all caused by viruses and are all regarded as primary pathogens. If your bird comes into contact with these viruses, even in very small numbers, the chances are good that they will become sick.
It gets even worse! There are no effective treatments for virus infections. The only treatments are to relieve the clinical symptoms, and to ensure that the bird gets as many nutrients and vitamins needed for the body of the bird to fight off the virus. The immune system of the bird is the only defense against a virus infection.
2. Bacteria

Bacteria seen under a normal light microscope. In this case this is a Bacillus species.
Bacteria growing on an agar plate. These were samples collected from floors.
Different bacteria growing on an agar plate collected from an area which had been previously disinfected.
Bacteria are capable of living freely in the environment. There are millions of bacteria around us each day. As mentioned above, the normal microbiota of the birds, which consist mainly of bacteria, play an important role in protecting the birds from infection by pathogenic bacteria. The normal microbiota of the birds physically occupy space in the upper respiratory tract and digestive tract of the birds. For a pathogenic bacterium to be able to attack the bird, they must first attach to the cells, which are covered by the normal microbiota.
Bacteria are capable of growing very rapidly and have a doubling time of about 20 – 30 mins. In other words, after a 24 hour incubation period, one bacterium can become many millions!
Pathogenic bacteria normally produce disease by producing strong toxins, which cause the disease symptoms. Most bacteria are opportunistic pathogens and only cause disease when the birds are under stress.
The most common bacterial pathogens in parrots include Salmonella species, Eschrichia coli, Streptococcus species, Staphylococcus species, Pasteurealla species and many others.
Fortunately, bacterial diseases can be treated with antibiotics. However, with the increasing misuse of antibiotics, there are more and more bacteria that are developing resistance to antibiotics. Increasing antibiotic resistance is becoming a very serious problem world-wide and there is increasing pressure to stop the use of antibiotics in animals (particularly the prophylactic use of antibiotic in animal feeds). The use and misuse of antibiotics will be covered in the next article in this series.
3. Fungi

The best known example of a fungus is the common bread mold which is seen when a slice of bread is left for a few days. There are a number of fungi which can cause problems with birds.
Fungi are eukaryotic organisms. This means that they have a cellular structure, which is not unlike the cellular structure of the birds and even humans. The fact that they have a similar cellular structure means that they are more difficult to treat than bacterial diseases.

Yeast are another group of micro-organisms. Generally not highly pathogenic.
Fungi reproduce by the production of millions of spores. These spores are very hardy and are difficult to get rid of.
Generally fungal infections in adult birds are not common. However one place where fungi can become a serious problem is in the incubation room. Fungi grow very nicely in the warm humid conditions in the egg incubator. Once fungi have established themselves in the incubator, they are very difficult to get rid of. Fungi are also of particular concern in very young birds, where they can establish an infection in the lungs and air sacs. Once established, it is virtually impossible to treat the fungal infection in the young bird.

An image of a yeast strain expressing the coat protein gene of Beak and feather disease virus. This was part of our successful effort to get a gene of BFDV expressed in the yeast as a possible vaccine.
Conclusions
In this first part, I have introduced you to the different types of disease causing agents which your parrots might come into contact with. I have briefly explained the main differences between viruses, bacteria and fungi. I have also explained the difference between primary pathogens and opportunistic pathogens.
In the next two parts of this series, I will concentrate on the different methods to control diseases. I will look at the pros and cons of treating with antibiotics. I will also look at vaccines and vaccine development and how vaccines can be used to control diseases. In the final part, I will discuss the use of biosecurity and disinfection as a way to control and limit infectious diseases. I will also discuss the development of a new product, which has been especially developed for use in birds, and the roll that this product can have on disease control.
For further information, you can contact me at BraggRR@ufs.ac.za
Virukill is a broad spectrum aldehyde free water sanitizer with potent bactericidal and fungicidal properties. With its superior composition and exceptional performance, Virukill offers you a reliable shield of protection.


